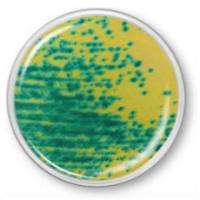
万古霉素耐药肠球菌显色琼脂（VRE）
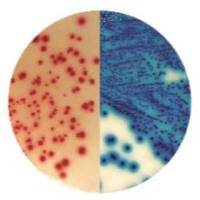
ESBL 显色培养基
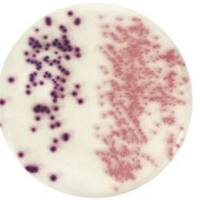
CCA 显色培养基
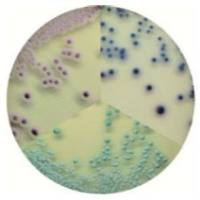
念珠菌显色培养基
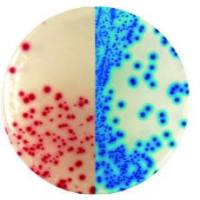
KPC 显色培养基
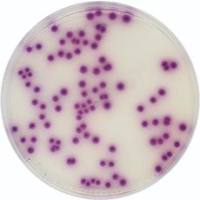
沙门氏菌显色培养基
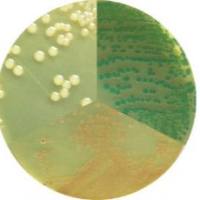
弧菌显色培养基

深圳子科生物科技有限公司 品牌商
9 年
手机商铺
商家活跃:
产品热度:
全部产品
- 查看全部分类
- ELISA酶联免疫检测试剂盒
- 农残类ELISA检测试剂盒
- 生化法检测试剂盒
- 抗体抗原
- 分子学试剂和检测试剂盒
- 细胞菌株
- 免疫学试剂
- 标准品对照品
- 进口标准品/对照品
- 生物培养基
- 生化试剂
- 细胞生物学试剂
- 病理染色液
- 荧光试剂
- 美国AMRESCO
- Qiagen试剂盒
- 美国BD
- 美国GENMED
- 美国G-BIOSCIENCES蛋白
- 美国MP
- CST抗体
- C&M biolabs
- 日本WAKO
- 美国RD
- 美国博世BioAssay Systems
- OXOID药敏试纸
- 生物耗材
- ABM GOOD
- 美国Moltox
- 美国Microbiologics-ATCC菌株
- 法国梅里埃鉴定卡及配套试剂
- ATCC原装菌株
- Omega Bio-Tek
- BioVision
- 法国科马嘉Chromagar显色培养基
- 西班牙 Condalab显色培养基
- 意大利利飞驰-liofilchem
- 印度海美迪HiMedia
- 美国ScienCell
- 澳大利亚ELISA Systems